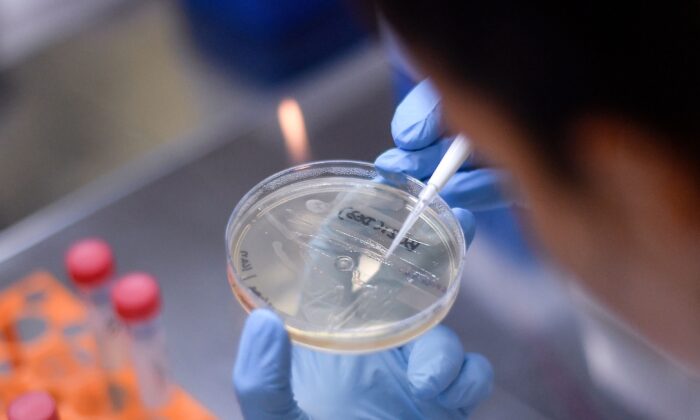

Vaccine COVID-19
- 22 August
Trung Quốc và Indonesia ký thỏa thuận chung về phân phối vaccine Covid-19
Theo hãng tin Antara, hôm 20/8 các nhà sản xuất vaccine Covid-19 ở Trung Quốc và Indonesia đã ký một biên bản ghi nhớ ưu tiên phân phối vaccine cho quốc gia Đông Nam Á…
- 21 August
Hãng dược Mỹ tuyển 60.000 tình nguyện viên thử vaccine Covid-19 tại 180 điểm
Trong bối cảnh dịch virus corona tiếp tục lây lan, các dự án vaccine cho Covid-19 đang được đẩy nhanh hết mức có thể. Tiếp theo hãng dược Moderna, Tập đoàn dược Johnson & Johnson…
- 21 August
Peru thử nghiệm diện rộng vaccine Covid-19 Trung Quốc, Mexico nhận thử nghiệm 2.000 liều vaccine Sputnik V của Nga
Peru thử nghiệm diện rộng vaccine Covid-19 Trung Quốc Tập đoàn Công nghệ Sinh học Quốc gia Trung Quốc (CNBG) ngày 19/8 cho biết, Cơ quan Y tế Peru đã phê duyệt thử nghiệm trên…
- 21 August
Papua New Guinea chặn công nhân Trung Quốc ‘đã’ tiêm vaccine Covid-19
Theo CNA hôm 20/8, Papua New Guinea đã chặn không cho một chuyến bay thuê riêng chở hơn 150 công nhân Trung Quốc hạ cánh, đồng thời yêu cầu phía Trung Quốc giải thích về…
- 19 August
Trung Quốc tiết lộ giá vaccine Covid-19 vào khoảng 144 USD/2 mũi tiêm
Ngày 18/8, ông Liu Jingzhen, Chủ tịch Tập đoàn dược quốc gia Trung Quốc Sinopharm cho biết, loại vaccine ngừa Covid-19 do tập đoàn này phát triển đang trong quá trình thử nghiệm lâm sàng…
- 18 August
3 tổng thống tình nguyện tiêm vaccine Sputnik V của Nga
Tổng thống Nicolas Maduro hôm 16/8 cho biết, ông sẽ là người đầu tiên ở Venezuela tiêm vaccine Sputnik V của Nga để "làm gương" trong cuộc chiến chống Covid-19. Hiện chưa rõ thời điểm…
- 17 August
Thời báo Hoàn Cầu: Trung Quốc cấp bằng sáng chế cho vaccine Covid-19
Thời báo Hoàn Cầu của Trung Quốc ngày 16/8 đưa tin, vaccine ngừa Covid-19 mang tên Ad5-nCoV do Công ty CanSino và quân đội TQ kết hợp phát triển đã được cấp bằng sáng chế…
- 16 August
Tin Covid-19 ngày 16/8 tại Thế giới: Hơn 50% bác sĩ Nga ‘không sẵn sàng’ để tiêm vaccine Sputnik V
Toàn thế giới ghi nhận tổng số hơn 21,5 triệu ca nhiễm viêm phổi Vũ Hán, trong đó có hơn 767.000 ca tử vong. Mỹ hiện là vùng dịch lớn nhất thế giới, ghi nhận…
- 16 August
Mexico tìm kiếm 200 triệu liều vaccine Covid-19 để thực hiện tiêm chủng toàn dân
Thứ trưởng Ngoại giao Martha Delgado, ngày 15/8 cho biết, Mexico sẽ cần tới 200 triệu liều vaccine Covid-19, và việc tiêm chủng cho 120 triệu dân của nước này có thể bắt đầu sớm…
- 15 August
Mạng xã hội Trung Quốc rao bán ‘vaccine Covid-19’ giá 71 USD/liều
Theo SCMP, trên mạng xã hội Wechat và nhiều nền tảng trực tuyến khác của Trung Quốc gần đây liên tục xuất hiện những bài viết quảng cáo, rao bán vaccine Covid-19 dù nước này…
- 15 August
Tin Covid-19 ngày 15/8 Thế Giới: EU đạt thỏa thuận mua 300 triệu liều vaccine Covid-19 từ AstraZeneca
Toàn thế giới ghi nhận tổng số hơn 21,3 triệu ca nhiễm viêm phổi Vũ Hán, trong đó có hơn 762.000 ca tử vong. Mỹ hiện là vùng dịch lớn nhất thế giới, ghi nhận…
- 15 August
Mỹ dự báo sẽ có vaccine sử dụng đại trà vào cuối năm, người dân được tiêm miễn phí
Bất kỳ loại vắc xin COVID-19 tiềm năng nào được hỗ trợ bởi chương trình "Chiến dịch phát triển vaccine thần tốc" (Operation Warp Speed) của chính quyền Trump khó có thể được các cơ…
- 15 August
Ba người Israel đầu tiên được điều trị bằng huyết tương hồi phục, xuất viện
Ngày 13/8, 3 bệnh nhân đầu tiên được điều trị bằng "vắc xin thụ động" COVID-19 mới, được phát triển bởi Trung tâm Y tế Hadassah và công ty dược phẩm sinh học Kamada của…
- 14 August
Tin Covid-19 thế giới ngày 14/8: Mexico thử nghiệm lâm sàng vaccine Covid-19 của Mỹ và Trung Quốc
Bộ Ngoại giao Mexico ngày 13/8 thông báo, nước này đang đặt mục tiêu tiến hành các thử nghiệm lâm sàng giai đoạn cuối đối với vaccine Covid-19 đang được phát triển bởi các công…
- 13 August
Tin Covid-19 thế giới ngày 13/8: Mỹ sẽ cung cấp 125 triệu khẩu trang có thể tái sử dụng cho các trường học
TT Trump cho biết ngày 12/8 rằng, chính phủ liên bang sẽ cung cấp tới 125 triệu chiếc khẩu trang có thể tái sử dụng cho các trường học trên khắp nước Mỹ. TT Trump…
- 13 August
Viện nghiên cứu Đức gỡ thông báo có thể có vaccine Covid-19 vào mùa thu
Viện Robert Koch - Viện bệnh truyền nhiễm hàng đầu của Đức hôm 12/8 đưa ra dự báo, vaccine Covid-19 sẽ được đưa ra thị trường vào mùa thu năm 2020 nhưng sau đó lại…
- 13 August
Nga sẽ ra mắt lô vaccine phòng Covid-19 đầu tiên trong 2 tuần tới; 10 USD cho 2 liều
Bộ trưởng Y tế Nga, ông Mikhail Murashko ngày 12/8 cho hay, lô vaccine phòng Covid-19 đầu tiên của Nga dự kiến ra mắt trong vòng 2 tuần tới, và nói thêm rằng mặc dù…
- 12 August
Tin Covid-19 ngày 12/8 Tại Mỹ: Mỹ ký hợp đồng mua 100 triệu liều vaccine ngừa Covid-19 với Moderna
Toàn thế giới ghi nhận tổng số hơn 20,4 triệu ca nhiễm viêm phổi Vũ Hán, trong đó có hơn 744.000 ca tử vong. Mỹ hiện là vùng dịch lớn nhất thế giới, ghi nhận tổng…
- 12 August
TT Putin tuyên bố Nga đã có vaccine Covid-19 đầu tiên
Tổng thống Nga, ông Vladimir Putin tuyên bố vào ngày 11/8 rằng, nước này đã phát triển loại vaccine đầu tiên cung cấp khả năng "miễn dịch vững vàng" chống Covid-19. Tổng thống Nga gửi…
- 11 August
Tin Covid-19 ngày 11/8 tại Mỹ: Mỹ sẽ chia sẻ vaccine Covid-19 với thế giới
Toàn thế giới ghi nhận tổng số hơn 20,2 triệu ca nhiễm viêm phổi Vũ Hán, trong đó có hơn 737.000 ca tử vong và hơn 13 triệu ca hồi phục. Nhiều nước châu Âu…
- 10 August
Khảo sát: 1/3 người Mỹ sẽ không tiêm vaccine Covid-19 dù miễn phí, GS Nhật sản xuất vaccine từ nhộng tằm
Trong khi nhiều nhà lãnh đạo và các chuyên gia y tế ra sức thúc đẩy để sớm có vaccine phòng Covid-19 thì dường như không phải ai cũng mong chờ điều đó. Theo khảo…
- 9 August
Chuyên gia dịch tễ Mỹ: Vaccine Covid-19 có thể chỉ có hiệu quả một phần
Tiến sĩ Anthony Fauci, chuyên gia hàng đầu về các bệnh truyền nhiễm của Hoa Kỳ cho biết: Nếu có một loại vaccine virus corona được phê duyệt thì cuối cùng cũng chỉ có thể…
- 5 August
Tin Covid-19 Thế Giới ngày 5/8
Toàn thế giới ghi nhận tổng số hơn 18,6 triệu ca nhiễm viêm phổi Vũ Hán, trong đó có hơn 704.000 ca tử vong. Mỹ hiện là vùng dịch lớn nhất thế giới, khi ghi nhận…
- 4 August
WHO cảnh báo: Có thể sẽ không bao giờ có ‘viên đạn bạc’ trị Covid-19
Tổng giám đốc WHO, ông Tedros và Giám đốc chương trình Y tế khẩn cấp của WHO, ông Mike Ryan hôm 3/8, hối thúc tất cả các quốc gia đẩy mạnh thực hiện các biện…
- 3 August
Tin Covid-19 tại Mỹ ngày 2/8: Vừa mở cửa ngày đầu, trường học Mỹ phát hiện học sinh nhiễm Covid-19
Harold Olin, hiệu trưởng trường trung học Greenfield-Central ở hạt Hancock, bang Indiana, Mỹ hôm 31/7 gửi email tới phụ huynh, xác nhận một học sinh của trường dương tính với virus Vũ Hán ngay…